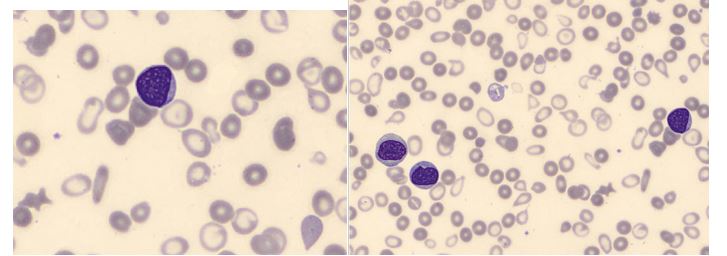

The patient is a 77 year old woman who presented in late Jan 2019 with severe anemia. In Feb 2017 she was diagnosed with myelodysplastic syndrome with no evidence of transformation to acute myelogenous leukemia. A bone marrow biopsy at the time showed 5-7% blasts in the bone marrow. She went through 5 rounds of chemotherapy with Vidaza (azacytidine) over the course of 9 months, with no significant response. She received one unit of RBCs with her 4th round of chemo and was given Aranesp (darbepoetin alfa) injections for anemia support. Aranesp is a man-made erythropoiesis stimulating protein which can be used to treat symptomatic anemia associated with myelodysplastic syndromes (MDS). After the 5th cycle of chemo, because of the lack of response, Vidaza was discontinued. Since then she has received several RBC transfusions to treat anemia and the Aranesp injections have continued.
In Oct 2018, the patient’s CBC showed leukocytosis, anemia, thrombocytopenia and neutrophilia. See results below:
Patient results 10/2018 reference ranges
WBC 31.6 4.5-10.5 x 103/μL
RBC 3.0 3.7-5.3 x 106/μL
Hgb 7.0 12.0-15.5 g/dl
Hct 23.6 36.0-46.0 %
MCV 78.4 80-100 fl
Plt 82 150-450 x 103/μL
The CBC with automated differential performed at this visit flagged for a smear review. The technologist suspected blasts and the slide was sent for a pathologist’s review. The pathologist’s interpretation was that the differential showed “an aberrant myeloblast population, representing 6% of leukocytes along with an immature appearing monocytic population with phenotypic aberrancies representing 21% of leukocytes.” A leukemia/lymphoma flow cytometry was ordered. Results of the flow cytometry commented that an acute myeloid leukemia could not be excluded, however the differential diagnosis could also include chronic myelomonocytic leukemia.
By Jan 2018, the patient was receiving blood transfusions every 6-8 weeks. CBC results from this visit shown below:
Patient results 1/2019 reference ranges
WBC 36.5 4.5-10.5 x 103/μL
RBC 2.7 3.7-5.3 x 106/μL
Hgb 6.2 12.0-15.5 g/dL
Plt 65 150-450 x 103/μL
Unfortunately the differential on this visit showed over 25% myeloblasts, confirmed by pathologist’s review. This sample was sent out for a second leukemia/lymphoma panel. A myeloblast phenotype was detected representing 27% of the leukocytes.
Diagnosis: Acute monoblastic/monocytic leukemia, no remission.

Myelodysplastic syndrome is a disorder of hematopoietic cell production involving clonal proliferation of an abnormal hematopoietic stem cell. It is most commonly diagnosed in patients in their 70s. Failure of the bone marrow to produce mature healthy cells is a gradual process, and therefore MDS is not necessarily a terminal disease. However, pancytopenia is a hallmark of MDS, and when pancytopenia is accompanied by the loss of the body’s ability to fight infections and control bleeding, MDS can be fatal. In addition, patients with MDS have a high risk of conversion to AML. About 30% of patients diagnosed with MDS will progress to acute myeloid leukemia (AML).
This patient was exhibiting pancytopenia, with accompanying anemia and infections, until her WBC began climbing several months ago. This was accompanied by the left shift and blasts seen on the peripheral smear, and prompted the flow cytometry studies.
Acute monoblastic/monocytic leukemia is considered a type of acute myeloid leukemia. In order to fulfill World Health Organization (WHO) criteria for AML-M5, a patient must have greater than 20% blasts in the bone marrow, and of these, greater than 80% must be of the monocytic lineage. AML-M5 can further be classified as M5a or M5b depending on whether the monocytic cells are predominantly monoblasts (>80%) or a mixture of monoblasts and promonocytes (<80% blasts).
The patient’s situation was discussed with the patient and her family. The patient chose more conservative and palliative treatment options over further chemotherapy.
References
http://wiki.clinicalflow.com/amol-acute-monoblasticmonocytic-leukemia-m5

-Becky Socha, MS, MLS(ASCP)CM BB CM graduated from Merrimack College in N. Andover, Massachusetts with a BS in Medical Technology and completed her MS in Clinical Laboratory Sciences at the University of Massachusetts, Lowell. She has worked as a Medical Technologist for over 30 years. She’s worked in all areas of the clinical laboratory, but has a special interest in Hematology and Blood Banking. When she’s not busy being a mad scientist, she can be found outside riding her bicycle.
Interesting case study